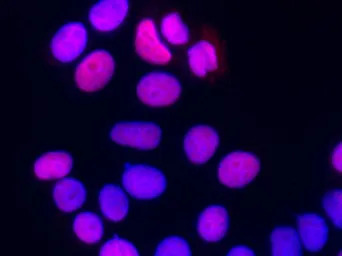
产品细节图片3

相关产品推荐更多 >
万千商家帮你免费找货
0 人在求购买到急需产品
- 详细信息
- 文献和实验
- 技术资料
- 免疫原:
Recombinant Human SUB1 / PC4 protein
- 亚型:
IgG1
- 形态:
Liquid
- 保存条件:
Store as concentrated solution. Centrifuge briefly prior to opening vial. For short-term storage (1-2 weeks), store at 4ºC. For long-term storage, aliquot and store at -20ºC or below. Avoid multiple freeze-thaw cycles.
- 克隆性:
Monoclonal
- 标记物:
Unconjugated
- 适应物种:
Human, Mouse
- 保质期:
12 months from the shipping date of the product.
- 抗原来源:
Human
- 目录编号:
GTX02053
- 级别:
Primary Antibodies
- 库存:
Available
- 供应商:
GeneTex
- 宿主:
Mouse
- 应用范围:
WB, ICC/IF, IP
- 浓度:
Batch dependent (Please refer to the vial label for the specific concentration.)
- 靶点:
PC4
- 抗体英文名:
PC4 antibody [04]
- 抗体名:
PC4 抗体 [04]
- 规格:
100 μl

IP analysis of HepG2 whole cell lysate using GTX02053 PC4 antibody [04].
IP antibody : 2 μl per 0.5 mg total whole cell lysate
Dilution : 1:100
50 % Protein G agarose : 15 μl

WB analysis of various samples using GTX02053 PC4 antibody [04].
Lane A : NIH-3T3 whole cell lysate
Lane B : Raji whole cell lysate
Dilution : 1:500
Loading : 30 μg
ICC/IF analysis of PFA-fixed MCF-7 cells using GTX02053 PC4 antibody [04].
Red : Primary antibody
Blue : DAPI
Dilution : 1:60
Permeabilzation : 0.3% Triton X-100
风险提示:丁香通仅作为第三方平台,为商家信息发布提供平台空间。用户咨询产品时请注意保护个人信息及财产安全,合理判断,谨慎选购商品,商家和用户对交易行为负责。对于医疗器械类产品,请先查证核实企业经营资质和医疗器械产品注册证情况。
 文献和实验
文献和实验Preclinical Development of AS04
was evidenced by higher vaccine-elicited antibody responses, as well as the induction of higher levels of memory B cells, as compared to aluminum alone formulations. Preclinical evaluation demonstrated the relevance of using AS04 in situations where high
(1 ). In our laboratory, we have developed methods to immortalize specific antibody-producing cells by fusing secreting EBV-activated lymphocytes to mouse-human heteromyeloma cell lines with electrofusion, followed by cloning (2 ). This methodology has allowed
抗子宫内膜抗体(endomethal antibody,EMAb)检测
子宫内膜抗体(endomethal antibody,EMAb)是子宫内膜异位病患者受到异位内膜的刺激,或经血逆流等因素导致免疫应答紊乱产生的一种自身抗体,并与子宫内膜中靶抗原结合,在补体参与下,引起子宫内膜免疫病理损伤,影响孕卵着床,也容易发生早期流产。目前检测EMAb的方法有间接免疫荧光法(1FT)、双向免疫扩散法(1D)、间接血凝法(PHA)及ELISA法等。IFF法需刮取子宫内膜制备抗原片,并需一定设备
 技术资料
技术资料暂无技术资料 索取技术资料







![TPO antibody [TPO/1922]](https://img1.dxycdn.com/2023/0711/451/6106825198874858761-14.jpg!wh200)

